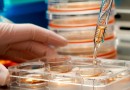
Биохимики научились превращать обычные клетки в стволовые при помощи кислоты

09 марта, 2014 / Светлана Дробышева, Редактор новостей

Большинство современных лекарственных препаратов имеет множество побочных эффектов. Как правило, это обусловлено тем, что лекарство всасывается в кровь и разносится по всему организму, оказывая действие не только в тех регионах, где это необходимо, но и в соседних, где оно может приносить вред.
Поэтому ученые все время ищут пути и способы доставки лечебных средств непосредственно к месту их применения. Это снизит вероятность неблагоприятных эффектов и повысит эффективность воздействия на основную цель. Кроме того, в этом случае
» » »
08 марта, 2014 / Светлана Дробышева, Редактор новостей

Нанотехнологии помогают решать серьезные медицинские проблемы. Как сообщает Science Daily, недавно ученым из Японии удалось создать уникальный материал, способный поглощать токсические вещества из крови человека.
На основе этого материала планируется создать устройство для очищения крови, которое можно будет использовать в домашних условиях как недорогую и удобную альтернативу аппарата для диализа «искусственная почка». Процедура диализа – наиболее распространенный метод помощи больным, почки которых не в состоянии вывести токсические продукты жизнедеятельности организма.
Однако диализ проводится обычно в
» » »
06 марта, 2014 / Светлана Дробышева, Редактор новостей

Ученые из университета Пенсильвании в Филадельфии добились успеха в проведении клинических испытаний нового метода лечения ВИЧ. У одного из 12 пациентов после генной терапии признаки инфицирования ВИЧ исчезли. Об этом сообщил еженедельный интернет-журнал Nature со ссылкой на статью из Journal of Medicine.
Уникальный пациент, Тимоти Браун, получил возможность контролировать ВИЧ-инфекцию еще в 2008 году, когда ему пересадили костный мозг от донора с мутацией гена CCR5. Ранее было известно, что люди с такой мутацией устойчивы к
» » »
06 марта, 2014 / Светлана Дробышева, Редактор новостей

Специалисты из университета Джонса Хопкинса пришли к выводу, что у пожилых пациентов с диабетом риск развития слабоумия не снижается, если проводится антигипертензивная терапия. Напротив, если агрессивно снижать давление до нормальных цифр, угроза становится более явной.
В статье, опубликованной изданием Los Angeles Times говорится, что такой вывод был сделан в ходе масштабного клинического исследования, посвященного поиску мер, улучшающих здоровье людей с высоким риском развития сердечно-сосудистых заболеваний.
Было показано, что среди тех, кто имеет высокое артериальное давление,
» » »
05 марта, 2014 / Светлана Дробышева, Редактор новостей

Биоинженеры из университета Цинциннати определили наиболее оптимальную частоту электростимуляции при лечении гнойных, плохо заживающих ран и разработали устройство, позволяющее оказывать эффективное воздействие.
Как известно, существуют такие болезненные состояния организма, при которых любая, даже самая незначительная рана может стать источником проблем на многие месяцы. В частности, при диабете, вследствие нарушений микроциркуляции, раны превращаются в язвы, которые часто гноятся и долго не заживают.
Обычная лекарственная терапия в таких случаях малоэффективна именно из-за плохого кровоснабжения в зоне такой
» » »
04 марта, 2014 / Анна Байкалова, Редактор новостей

Пластырь, который сможет отслеживать основные физиологические функции пациента, будет массово испытан в ближайшие месяцы в 10 больницах, принадлежащих Национальному институту здоровья Великобритании.
Как сообщает Daily Mail, пластырь представляет собой электронное устройство, способное снимать показатели давления крови, параметры дыхания, частоту сердечных сокращений и температуру тела. Каждые две минуты данные посредством беспроводной сети передаются на компьютер и на мобильные устройства дежурных медсестер.
Устройство SensiumVitals выполнено в виде одноразового пластыря, который крепится на грудь пациента. Стоимость прибора 35
» » »
01 марта, 2014 / Наталья Малецкая, Редактор новостей

Нанокерамический протез, обладающий свойствами природной кости, был изготовлен учеными Томского Государственного Университета совместно со специалистами из Института физики прочности и материаловедения. Высокотехнологичный аналог полностью идентичен костям человека, и потому протезы из этого материала не отторгаются организмом.
Сергей Кульков, являющийся завкафедры прочности и проектирования ФТФ ТГУ, сообщил, что новый материал был получен в рамках госзаказа Минпромторга. Ученый также рассказал об основных свойствах и способах его получения.
За основу ученые взяли нанокерамику, представляющую собой уникальный пористый материал,
» » »
28 февраля, 2014 / Светлана Дробышева, Редактор новостей

Ученые из Каролинского института в Швеции доказали, что развитие атеросклеротических бляшек можно повернуть вспять. Однако для этого следует не упустить момент – такие процессы возможны только на ранней стадии атеросклероза. Как сообщается в новостях Science Daily, основной пусковой механизм регресса жировых отложений в сосудах – снижение уровня «плохого» холестерина (ЛПНП).
Проведенные исследователями эксперименты на лабораторных животных показывают, что превентивное поддержание уровня ЛПНП на низком уровне предотвращает образование атеросклеротических бляшек. Кроме того, ученые с удивлением обнаружили,
» » »
28 февраля, 2014 / Светлана Дробышева, Редактор новостей

Способ избавления от изжоги предлагают специалисты из клиники Stony Brook University. Механическое устройство, напоминающее браслет, надевается на нижнюю часть пищевода чуть выше желудка. Это улучшает барьерную функцию пищеводного сфинктера и не позволяет ему раскрываться после попадания пищи в желудок. Установка браслета требует небольшой эндоскопической операции.
Простое механическое устройство представляет собой эластичную ленту, содержащую титановые шарики с магнитными сердечниками. Магнитное притяжение позволяет свободно проходить кускам пищи, но после этого заставляет сфинктер пищевода смыкаться, не пропуская из
» » »
26 февраля, 2014 / Светлана Дробышева, Редактор новостей

Очутиться в мире виртуальной реальности – давняя мечта всех компьютерных игроманов. Однако в последнее время появляется все больше разработок, ставящих эту технологию на службу здоровья человека. Medical Xpress сообщает, что в технологическом университете Чалмерс разработана методика лечения фантомных болей, компонентом которой является технология дополненной реальности.
Люди, которые теряют руку или ногу нередко (в 70% случаев) страдают от болей в конечностях, которых уже нет в реальности. Так называемые, фантомные боли ощущаются достаточно интенсивными и значительно снижают
» » »
26 февраля, 2014 / Светлана Дробышева, Редактор новостей

Разработанная в университете Вашингтона в Сент-Луисе, инновационная «рубашка» для сердца позволит решить многие вопросы эффективной диагностики и лечения болезней сердца. Результаты работы команды биоинженеров, возглавляемой Игорем Ефимовым, опубликованы вчера в издании Nature Communications.
Новое устройство представляет собой тонкую эластичную пленку из силикона, которая «надевается» на сердце и точно повторяет индивидуальные особенности его внешней оболочки (эпикарда). Пленка легко растягивается, не мешая сердцебиениям, однако плотно фиксируется без дополнительного крепления.
Эластичная «рубашка» является платформой для установки различных электронных,
» » »
25 февраля, 2014 / Наталья Малецкая, Редактор новостей

Скорость и масштабы распространения онкологических заболеваний заставляют искать новые способы борьбы с этой смертельной болезнью. Недавно ученые Вашингтонского университета создали очки, которые позволяют хирургам видеть раковые клетки. А сотрудники Массачусетского технологического института заявили о новом подходе в диагностике онкологических болезней.
Теперь наличие рака у человека можно будет определить по анализу его мочи. Сам анализ занимает несколько минут и проводится при помощи специальных тестовых полосок.
Процедура очень похожа на ту, что используется для определения беременности. Разница
» » »
24 февраля, 2014 / Светлана Дробышева, Редактор новостей

Усовершенствование, предлагаемое командой исследователей из датского университета Орхуса для магнитно-резонансной томографии (МРТ) с гиперполяризацией, позволит безопасно и эффективно отслеживать изменения обменных процессов в клетках организма, приводящих развитию различных болезненных состояний.
Как сообщает Medical Xpress, в международном журнале Kidney International опубликована статья, в которой ученые доложили о результатах сравнения модернизированного МРТ-сканирования клеток почек крыс с диабетом. Оказалось, что клетки больных животных по-иному усваивают кислород, чем почечная ткань здоровых крыс.
Ученые отмечают, что теперь появится возможность снимать
» » »
24 февраля, 2014 / Светлана Дробышева, Редактор новостей

Найдено еще одно научное подтверждение исключительной эффективности древнекитайских методик врачевания. На этот раз ученые из медицинской школы Рутгерс в Нью-Джерси в ходе исследований обнаружили, что акупунктура (иглоукалывание) помогает лечить серьезные воспалительные заболевания, в том числе смертельно опасный сепсис, который иногда называют «заражением крови».
Как рассказал изданию ScienceDaily один из авторов исследования, иммунолог Луис Улла, сепсис – наиболее частая причина внутрибольничной смертности, в США ежегодно уносит жизни около 250 тысяч пациентов. Однако во многих случаях не
» » »
21 февраля, 2014 / Светлана Дробышева, Редактор новостей

В Лондоне решили окончательно прояснить вопрос об эффективности лечения инфаркта стволовыми клетками. Ученые называют свою программу исследований на эту тему судебным процессом, в результате которого появится обвинительное или оправдательное решение. В ходе научной работы будет установлено, насколько сильно сокращается смертность от инфаркта в результате такого лечения и удается ли восстанавливать разрушенные инфарктом ткани сердца.
Испытания будут проходить в клиниках одиннадцати европейских стран, сообщает BBC. В них примут участие три тысячи пациентов с диагнозом «инфаркт миокарда».
» » »
21 февраля, 2014 / Анна Байкалова, Редактор новостей

Для большинства женщин наступление менопаузы означает появление ряда симптомов, среди которых самый неприятный и тяжело переносимый - приливы жара. Для облегчения состояния в этот период обычно используют заместительную гормональную терапию, но она подходит не всем.
В исследовании, проведенном при поддержке Национального института здоровья в Северо-Западном университете в Чикаго, похоже, найден новый метод для решения этой проблемы негормональными средствами.
Метод называется блокадой звездчатого ганглия и часто применяется для снятия болей. Некоторые женщины, которые получали обезболивающие инъекции
» » »
20 февраля, 2014 / Светлана Дробышева, Редактор новостей

Известный индийский изобретатель и предприниматель Мир Имран надеется помочь больным, страдающим диабетом и другими хроническими заболеваниями, требующими частых инъекций. Его новая разработка – автоматизированная пилюля. Будучи принятой через рот, она безопасно впрыскивает лекарственное вещество в богатую сосудами стенку тонкого кишечника.
Как пишет Fox News, пилюля представляет собой капсулу, стенки которой изготовлены из биорастворяемого полимера. Внутри капсулы находятся микроиглы из сахара, «заряженные» определенной дозой лекарства, а также два резервуара с микродозами лимонной кислоты и соды.
Таблетка
» » »
20 февраля, 2014 / Анна Байкалова, Редактор новостей

Перелом шейки бедра - тяжелая травма, требующая длительного лечения и реабилитации. Наиболее часто такой перелом происходит у женщин пожилого возраста, страдающих остеопорозом, что еще более затрудняет выздоровление.
В исследовании, опубликованном 19 февраля в Journal of the American Medical Association, утверждается, что программа упражнений, выполняемых пациентами дома после выписки, позволяет достичь лучших результатов в реабилитации. Комплекс упражнений включал в себя шаги по ступеням, вставание со стула и т.п.
Результаты были получены наблюдением за 232 пациентами пожилого
» » »
18 февраля, 2014 / Светлана Дробышева, Редактор новостей

Найдено новое средство, помогающее ограничить повреждения сердечной мышцы при инфаркте миокарда. Как сообщает Daily Mail, американские и австралийские ученые разработали новые микрочастицы, которые уменьшают зону формирования постинфарктных рубцов. Введенные в кровоток в течение первых суток после сердечного приступа, они захватывают излишне активные воспалительные клетки и выводят их из организма.
Во время сердечного приступа, когда все тело человека пребывает в состоянии напряжения, иммунная система выбрасывает в кровь огромное количество моноцитов – белых кровяных клеток, помогающих справиться
» » »
18 февраля, 2014 / Светлана Дробышева, Редактор новостей

Ученым удалось создать прототип прибора, который улучшит состояние донорских органов во время их транспортировки. До настоящего времени врачи перевозили их в контейнерах со льдом, сохраняло жизнеспособность на весьма непродолжительное время. Любая задержка в пути могла превратить ценный груз, призванный спасти чью-то жизнь в бесполезные биологические отходы.
Как сообщило новостное издание NPR, команда медиков и инженеров компании Andover из американского штата Массачусетс, разработала экспериментальное устройство, позволяющее имитировать нормальную функцию органов во время транспортировки. В результате к
» » »
17 февраля, 2014 / Анна Байкалова, Редактор новостей

Регенеративная медицина стремительно развивается последние годы. Только недавно сообщалось о создании почти полноценной человеческой кожи, а на прошлой неделе CNN опубликовал новость о прорывном достижении в выращивании легких человека.
Ученым из Техасского университета основой для создаваемого органа послужили легкие двух детей, погибших в автоаварии. Из-за сильного повреждения эти легкие не могли быть использованы для пересадки.
Одно донорское легкое было специальным образом освобождено от основного содержимого, в результате чего остался «скелет» будущего органа из коллагена и
» » »
16 февраля, 2014 / Анна Байкалова, Редактор новостей

Цифровая эра привнесла много новинок в медицину и существенно изменила труд врачей. Сейчас возможности связи позволяют в некоторых случаях заменить первичный прием у врача почти равноценной консультацией по электронной почте.
Ученые из Перельмановской школы медицины при Университете Пенсильвании работают над проектом, который они назвали «Теледерматология». Благодаря их разработкам люди из отдаленных районов, лишенные возможности посетить дерматолога, смогут отправить врачу снимок тревожащей их родинки или необычных высыпаний. Разработчики полагают, что система обеспечит такой же эффект, как
» » »
11 февраля, 2014 / Светлана Дробышева, Редактор новостей

Гормональная заместительная терапия, которую назначают женщинам в период менопаузы, способна не только сгладить неприятные симптомы, связанные с климаксом, но и предотвратить быстрое старение мозга. Об этом сообщило новостное агентство Fox News со ссылкой на результаты работы исследователей из Луизианы.
Специалисты из Тулейнского университета в процессе экспериментов на лабораторных крысах моделировали процессы, происходящие у женщин в постменопаузе как с использованием гормонального лечения, так и без него. Оказалось, что животные, получавшие эстроген, демонстрировали лучшие результаты в тестах
» » »
07 февраля, 2014 / Светлана Дробышева, Редактор новостей

В Израиле разработан прототип контактной линзы, которая позволит незрячим людям научиться различать окружающие объекты, читать, обходить препятствия, узнавать знакомые лица. Об этом на страницах издания Daily Mail рассказал автор изобретения, профессор Зеев Залевски.
Применять «офтальмологическое чудо» можно, не прибегая к оперативному вмешательству. Кроме того, в отличие от предлагаемых в последнее время моделей «бионического глаза» использовать его могут и люди, слепые от рождения, чьи зрительные пути остаются в неразвитом состоянии.
Выглядит новинка как обычная контактная линза
» » »
07 февраля, 2014 / Анна Байкалова, Редактор новостей

«Революционные медицинские технологии» - так расшифровывает свое название американская компания RevMedx, предложившая новые материалы и технологии остановки кровотечений при ранениях. Предполагается, что средства, в основе которых губчатый материал, станут использоваться в американской армии.
Набор XStat способен остановить кровотечение в огнестрельных ранах за 15 секунд. Губчатые кусочки, вводимые в рану с помощью шприца-аппликатора, впитывают кровь и моментально увеличиваются в объеме.
Масса изнутри давит на ткани и таким образом останавливает кровотечение. Аппликатор изготавливается в двух размерных модификациях:
» » »
06 февраля, 2014 / Светлана Дробышева, Редактор новостей

Теперь имеется научное подтверждение тому, о чем догадывались многие: если человек лишается возможности видеть, то слух у него становится лучше. Яркие примеры, подтверждающие теорию – долгая и успешная эстрадная карьера слепых певцов, таких как Рэй Чарльз и Стиви Уандер. Ученые из института Мозга при университете Джонса Хопкинса и Мэрилендского университета доказали справедливость теории в эксперименте на лабораторных мышах.
О том, как проходила научная работа и каковы ее результаты, каналу Fox News рассказали авторы исследования Хэй-Кьянг
» » »
04 февраля, 2014 / Светлана Дробышева, Редактор новостей

Последнее открытие в области иммунологии поможет диагностировать рак крови на стадии, когда он еще не развился. Австралийские исследователи из института Уолтера и Элизы Холл доказали, что клетки иммунной системы любого человека постоянно, каждый день занимаются уничтожением клеток с мутациями, у которых есть все шансы стать раковыми. Об этом сообщил медицинский портал Drugs.com со ссылкой на публикацию статьи в журнале Nature Medicine от 2 февраля.
Как отмечают авторы открытия, у каждого человека в норме в крови
» » »
01 февраля, 2014 / Анна Байкалова, Редактор новостей

Швейцарские ученые добились нового качества кожи, создаваемой биоинженерными методами. Выращенная ими кожа имеет не только капилляры, но и лимфатические сосуды. Без нормально функционирующих лимфатических сосудов в тканях накапливается серозная жидкость, и это может погубить трансплантат, прежде чем он приживется.
Даниэла Марино, возглавившая исследовательскую группу в детской клинике при Цюрихском университете, говорит, что новое достижение «открывает широкий спектр возможностей в области тканевой инженерии, так как все органы в теле человека - за исключением головного мозга и
» » »
30 января, 2014 / Наталья Малецкая, Редактор новостей

Совместная работа исследовательских команд биологов двух стран – США и Японии – привела к прорыву в области изучения стволовых клеток. Теперь их можно получать из обычных клеток без вмешательства в работу генов.
Новый способ получения стволовых клеток основан на перепрограммировании обычных клеток, не затрагивая внутренние механизмы их работы. Как сообщает издание Nature, отличительной особенностью нового метода является полное невмешательство в работу генов.
Исследовательские площадки разместились в японском Институте RIKEN и Гарвардском университете США. В ходе
» » »
28 января, 2014 / Наталья Малецкая, Редактор новостей

Европейские СМИ пестрят заголовками: «Рак груди можно вылечить без операции». Поводом для подобного ажиотажа послужило открытие британских медиков, которое дает надежду на выздоровление тысячам пациенток с этим страшным диагнозом.
Ученые британского медицинского центра выделили так называемый белок выживания, который находится в организме женщины. Если данный белок использовать специальным образом, то он может эффективно бороться с раком груди даже без оперативного вмешательства.
Речь идет об особом белке DACH1. Он есть практически у всех женщин, которые в
» » »
27 января, 2014 / Наталья Малецкая, Редактор новостей

Американские исследователи обнаружили, что музыкальное творчество помогает молодым пациентам онкологических клиник легче переносить лечение. Работа опубликована в журнале Cancer.
В обследуемую группу были отобраны пациенты, перенесшие пересадку стволовых клеток (которые дают начало не только клеткам крови, но и другим органам), в возрасте от 11 до 24 лет. Они под руководством опытного музыкального терапевта трудились над созданием собственного музыкального клипа. По завершении работы состоялись «премьеры» клипов, на которые были приглашены родственники и друзья.
Выяснилось, что члены
» » »